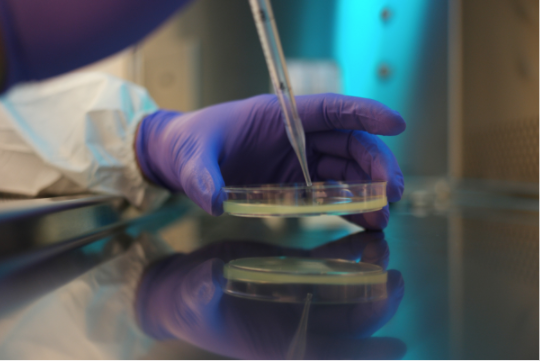

What is Aseptic Technique?
Raise your hand if you’re tired of doing chores! Washing dishes, doing laundry, or cleaning your room may be boring, but it’s important to keep your living area clean and safe. You probably wouldn’t want to eat your dinner with a dirty spoon! If we’re in the microbiology lab, we also must be careful to keep our utensils clean, so that our experiments go well. There is a fancy name for this, and it’s aseptic technique. The main rules are to sterilize everything and hold on to all your utensils- don’t set them down until you’re done. We have to practice aseptic technique in various situations.
When we transfer broth from a bottle to a tube, or between two tubes, we might use a pipette. Do not set the pipette down between transfers. It’s a good idea to keep it in its plastic package so the tip doesn’t touch any surfaces, like the bench, that are teeming with bacteria! Hold on to the tube and bottle caps when you're transferring. Sterilize the tops of the tubes or bottles by passing them through a flame. The broth can be used to grow bacteria, so we want to ensure that there aren’t any extra bacterial species there already.
When we place a species of bacteria on a petri dish or in a test tube, we use an inoculating loop or needle. Put the loop or needle into an incinerator or a flame for a few seconds, take it out and hold on to it while it cools down. After a few seconds, you can transfer the bacteria. Sterilize again. Do not set the loop or needle down on the bench or wave it around until you’re done with the final sterilization. We want to make sure that we’re only transferring that particular species, and no extra bacteria- that could interfere when we’re making observations of the species! For example, if we're doing a Gram stain, what if our species of interest is negative with a pink stain, but the extra bacteria is positive with a purple stain? Seeing the two colors would be confusing and lead to inaccurate results!
The most important part of aseptic technique is keeping ourselves safe. That’s why we have many protocols, such as washing our hands before and after working with bacteria, and only wearing the lab coat in the lab. Even though we can’t see them, bacteria are everywhere!